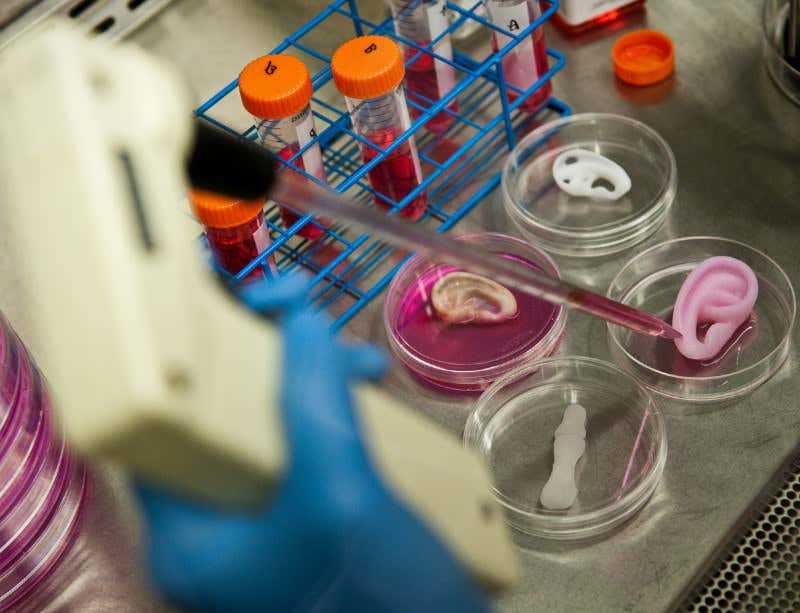
New Scientist. Science news and long reads from expert journalists, covering developments in science, technology, health and the environment on the website and the magazine.

Damaged ears could be replaced with made-to-measure organs grown in a dish (Image: Andrew Craft)
WHEN the tracheal cancer reappeared, doctors agreed that Andemariam Teklesenbet Beyene’s golf ball-sized tumour was inoperable. So one of them suggested a treatment that was rather different: building him a new windpipe, from scratch.
Researchers around the world are making groundbreaking progress in engineering replacement organs. Since the first successes with bioengineered skin – which can be used for grafts to treat people with burns, for example – tissue engineers have created lab-grown cartilage, bone and, most recently, whole organs such as bladders.
“Scientists genuinely believe that in years to come, labs will be filled with rows of hearts and livers that can be taken off the shelf and tailored to you,” says Lindsey Dew, who has just started a PhD in tissue engineering at the University of Sheffield. “Tissue engineering is the future of medicine.”
Advertisement
In years to come, labs will be filled with rows of hearts and livers that can be taken off the shelf
Building organs
Engineering an organ usually means starting with a scaffold to supply the basic structure. This is often donated. The team behind the world’s first bioengineered windpipe transplant, for example, started this way, stripping the donor’s cells from the structure before seeding it with stem cells from the recipient’s bone marrow. Stem cells can be encouraged to develop almost any type of cell, given the right environment, and once the recipient’s cells had populated the scaffold, it could be transplanted.
Unlike donated organs, those custom-made in this way are not rejected by the body. That means recipients are spared a lifetime of taking immune-suppressing drugs.
Tissue engineers now hope to bypass lengthy waits for donor organs by using synthetic scaffolds. One of the first successes came two years ago, when a team at Karolinska University Hospital in Stockholm, Sweden, transplanted a synthetic windpipe for the first time. Beyene was the lucky recipient.
The trachea was developed by Alexander Seifalian and his colleagues at University College London. With a background in nuclear physics, Seifalian also studied nuclear medicine and biochemistry before settling on tissue engineering. “It’s the next generation of medical treatment,” he says. “When you’re developing organs, you’re saving lives and improving people’s lives. That got me excited.”
His team built the organ in just 10 days. Seifalian first crafted a glass mould of Beyene’s windpipe based on a CT scan, then the team used the mould to create a replica made from porous polymers. They coated this scaffold with growth factors – chemical cues to goad stem cells into becoming specific cell types – then soaked the structure in a solution of stem cells extracted from Beyene’s bone marrow. During this time, the cells take hold in the scaffold’s millions of tiny holes. Today, Beyene remains in good health. “It was the highlight of my life,” says Seifalian.
Since then, Seifalian’s team has built tear ducts and bypass grafts from similar materials. Lab-grown urethras, coronary arteries, heart valves and stents are next.
Other groups are creating new organs by printing them. Ben Shepherd and colleagues at Organovo, a bioengineering company based in San Diego, California, used a 3D printer loaded with human cells to build a functional “mini-liver”. Although only a few millimetres wide and a mere half a millimetre thick, it produced detoxification enzymes just like a full-sized liver.
Body shop
Seifalian’s long-term ambition is to scale up production. “It would be virtually like having a shop,” he says. “People could order an organ and I would make it and send it to them.” Organs such as windpipes, ears or noses would ideally still be made to measure, but blood vessels or heart valves could be manufactured in various standard sizes.
One of the main challenges is ensuring these newly built organs have enough of a blood supply to keep them alive. For her PhD project, Dew is developing experimental and computational models to look for ways to accelerate blood vessel growth in skin grafts.
“With tissue engineering, there’s a real push to take research out of the lab and into the clinic,” says Dew. “I love the idea that my work will have an impact on patients’ lives.”
A truly multidisciplinary subject, tissue engineering requires the skills of chemists and materials engineers to design and build organ scaffolds, physicists and mathematicians to model tissue growth, and biologists to monitor and control cell growth. “Sitting in my team now we have physicists, engineers, mathematicians, pharmacologists, biologists and surgeons, and we collaborate with other clinical staff,” says Seifalian.
At the moment, most UK tissue engineering research takes place in universities, and much of the funding comes from organisations supporting the development of bioengineered organs for drug testing, including the National Centre for the Replacement, Refinement and Reduction of Animals in Research (NC3Rs) and the EU’s Innovative Medicines Initiative. NC3Rs provides PhD studentships and early career fellowships at UK universities.
The biggest UK employers in industry are Smith & Nephew, a research company focused on wound care, and drug company Pfizer, whose research includes developing stem cell therapies for Crohn’s disease.
Postdocs can get in on the action by creating their own opportunities, says Jamie Davies, who is attempting to engineer kidneys at the University of Edinburgh. “Find a really strong group that has not yet got tissue engineering and be the one who starts it,” he suggests.
“It’s a great time to pitch in,” says Shepherd. “You’re starting to see things happen that people have been talking about the last 10 to 15 years. It’s really exciting.”
Build your own food, too
Mark Post’s burger recipe is somewhat unconventional. He starts by collecting stem cells from cow muscle. Post’s team at Maastricht University in the Netherlands then coaxes them into multiplying to form small strips of muscle tissue. “If you make sufficient numbers of those, you have enough to make a hamburger,” he says.
It may seem far-fetched, but in-vitro meat offers a solution to some pressing global issues, notably feeding hungry mouths as the world’s population rises. “Meat production has met its maximum, but demand is going to double in the next 20 to 40 years,” says Post. Swapping livestock for test tubes would also slash the emission of greenhouse gases belched out by the animals, and avoid the welfare issues associated with farming.
Post’s first burger took three months to manufacture and cost an indigestion-inducing €260,000, but he hopes to refine the procedure until it is more cost-effective than rearing animals for food.
“It’s really promising as a first step for the future of cultured meat,” says Marianne Ellis, a biochemical engineer at the University of Bath. Her team is developing devices called bioreactors that aim to provide the ideal conditions for tissue growth. These systems could scale up the production of in-vitro meat, she says.
Current opportunities for aspiring meat engineers are few and far between, but Post hopes that the publicity generated by his burger will whet the appetites of other research groups and funding bodies. “I’m pretty sure that five years from now, it’ll be pretty big,” he says. By then, in-vitro meat might already have hit supermarket shelves, says Ellis.
This article appeared in print under the headline “Grow your own”
Topics:



